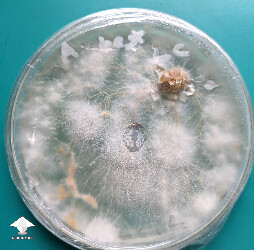
Sclerotia forming on a P. mexicana LC test plate

Photo collection of magic truffles aka Philosopher's stones. In fact they are sclerotia — a dense form of mycelium that helps fungi to survive in hot, dry seasons. The certain species of Psilocybe mushrooms form sclerotia and contain psilocybin, psilocin
Magic Truffles gallery on Shroomok

Load more photos
Shroomok's choice on Amazon
Premium Food Dehydrator Machine - Digita...
Wide Mouth Mason Jar Plastic Lid + Syrin...
NOW Foods Agar Powder, 5 Ounce
Amazon Grocery, Brown Long Grain Rice, 5...
Humidity Controller
SpawnBrawn Sterilized Rye Grain Berries...
Karo, Syrup Corn Light With Vanilla, 16...
Root Mushroom Farm- Mushroom Liquid Cult...
Hoffman Canadian Sphagnum Peat Moss
Smart Plug, Smart Home - 2 Pack
Barton Pressure Pressure Cooker, 22 Qt
INTLLAB Magnetic Stirrer with 7PCS stir...



